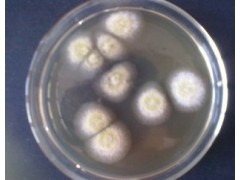

性状:黄绿色或者黄色粉末
有效活孢子含量≥20亿∕克。
Aspergillus oryzae ( Asp.oryzae)
半知菌亚门,丝孢纲,丝孢目,从梗孢科,曲霉属真菌中的一个常见种。
米曲霉菌落生长快,10d直径达5~6cm,质地疏松,初白色、黄色,后变为褐色至淡绿褐色。背面无色。分生孢子头放射状,一直径150~300μm,也有少数为疏松柱状。分生孢子梗2mm左右。近顶囊处直径可达12~25μm,壁薄,粗糙。顶囊近球形或烧瓶形,通常40~50 μm。小梗一般为单层,12~15μm,偶尔有双层,也有单、双层小梗同时存在于一个顶囊上。分生孢子幼时洋梨形或卵圆形,老后大多变为球形或近球形,一般4.5μm,粗糙或近于光滑。分生孢子梗长约2mm,近顶囊处直径达12~25μm,壁薄而精糙。顶囊近球形或烧瓶形,直径40~50μm,上覆单层小梗。分生孢子幼时洋梨形或随圆形,成熟后为球形或近球形,直径4.5~7.0μm,表面粗糙或近于光滑。分生孢子头直径150~300μm。
菌落生长较快,质地疏松。初呈白色、黄色,后转黄褐色至淡绿褐色,背面无色,分布甚广,主要在粮食、发酵食品、腐败有机物和土壤等处。是我国传统酿造食品酱和酱油的生产菌种。也可生产淀粉酶、蛋白酶、果胶酶和曲酸等。
米曲霉是一类产复合酶的菌株,除产蛋白酶外,还可产淀粉酶、糖化酶、纤维素酶、植酸酶等。在淀粉酶的作用下,将原料中的直链、支链淀粉降解为糊精及各种低分子糖类,如麦芽糖、葡萄糖等;在蛋白酶的作用下,将不易消化的大分子蛋白质降解为蛋白胨、多肽及各种氨基酸,而且可以使辅料中粗纤维、植酸等难吸收的物质降解,提高营养价值、保健功效和消化率。
用途:广泛应用于食品酿造、饲料添加、生物肥料添加、生产曲酸、酿酒等发酵工业。